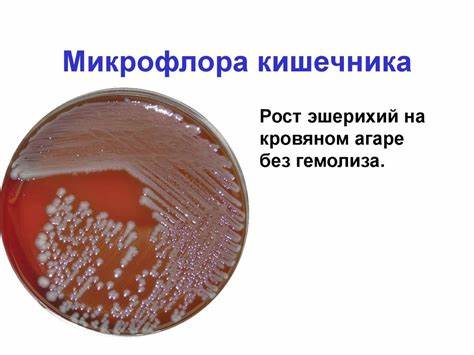

Диета и микрофлора кишечника
Картинка 2: Микрофлора кишечника: восстановление, препараты, список, инструкция по
Картинка 3: Заболевания желудочно-кишечного тракта. Профилактика - презентация онлайн
Картинка 4: Здоровая диета для кишечника и желудка
Картинка 5: Холин/Инозитол капсулы 500мг/500 мг | Solgar - полезные свойства
Картинка 6: Микрофлора тела человека - презентация онлайн
Картинка 7: Микрофлора кишечника и здоровье человека
Картинка 8: L-Глутамин таблетки 1000 мг 60 шт | Solgar - полезные свойства
Картинка 9: Как повысить иммунитет кишечника быстро и эффективно
Картинка 10: Микрофлора тела человека - презентация онлайн
Картинка 11: Микрофлора кишечника и здоровье человека
Картинка 12: Диета при воспалении кишечника, полезные и вредные продукты
Картинка 13: Нормальная микрофлора кишечника: МИКРОБНАЯ ФЛОРА КИШЕЧНИКА И
Картинка 14: Микрофлора тела человека - презентация онлайн
Картинка 15: Микрофлора кишечника
Картинка 16: Микрофлора тела человека - презентация онлайн
Картинка 17: Диета при остром панкреатите: примерное меню на каждый день
Картинка 18: Микрофлора кишечника. История изучения, состав, функции, методы оценки
Картинка 19: Кандидоз кишечника: симптомы, лечение, диета
Картинка 20: Микрофлора желудочно-кишечного тракта
Картинка 21: Микрофлора кишечника – главный регулятор мозга
Картинка 22: Микрофлора кишечника человека, ее восстановление и нормализация
Картинка 23: Чем лечить воспаление кишечника - диета, препараты, народные методы
Картинка 24: Микрофлора кишечника. История изучения, состав, функции, методы оценки
Картинка 25: Диагностика дисбактериоза кишечника: как выявляют заболевание
Картинка 26: Что такое патогенная микрофлора человека?
Картинка 27: Лактофлор Био Плюс Пробиотик + Пребиотик за стомашно-чревен комфорт
Картинка 28: Нормальная микрофлора кишечника
Картинка 29: Диета При Болезни Кишечника Меню — Похудение Диета Правильное Питание
Картинка 30: Геморрой и синдром раздраженного кишечника
Картинка 31: Препараты для нормализации и восстановления микрофлоры кишечника
Картинка 32: Что такое микрофлора кишечника Здоровье и медицина Другое
Картинка 33: Микрофлора кишечника (витафлора и некрофлора). Свобода от гниения
Картинка 34: Болезнь Крона и микрофлора кишечника
Картинка 35: Микрофлора кишечника. Дисбактериоз - презентация онлайн
Картинка 36: Аминокислотная Реконструкция Волос - основная коллекция фотографий
Картинка 37: Фиточай Фитал 6 Чага микс (желудочный) ф/п 1,5х20 | Зеленая аптека
Картинка 38: Дисбактериоз кишечника, сиптомы, лечение у взрослых и детей
Картинка 39: Микрофлора кишечника | Полезная информация | ЦДО InstructorPRO
Картинка 40: Что такое микрофлора кишечника? / Почему происходит нарушение
Картинка 41: МИКРОФЛОРА КИШЕЧНИКА и пробиотики - Nutrifactor Academy
Картинка 42: Как ВОССТАНОВИТЬ микрофлору кишечника БЕЗ лекарств: 10 способов
Картинка 43: К мозгу через кишки. Микрофлора кишечника и аутизм. | STENA.ee
Картинка 44: Белковая Диета При Циррозе Печени С Асцитом — Похудение Диета
Картинка 45: Спирулина | Solgar - полезные свойства, инструкция по применению, где
Картинка 46: Лучшие пробиотики для восстановления микрофлоры кишечника - список
Картинка 47: Запор и КЕТО диета. Микрофлора кишечника и Пробиотики. Синдром дырявого
Картинка 48: Микрофлора кишечника и здоровье - ФОТО (R)
Картинка 49: Синдром Раздраженного Кишечника Симптомы И Лечение Диета — Похудение
Картинка 50: Хронический Колит Лечение Препараты И Диета Кишечника — Похудение Диета
Картинка 51: Как улучшить здоровье? Микрофлора кишечника – самое главное
Картинка 52: Микрофлора кишечника | Грибы, Здоровье, Лекарственные средства
Картинка 53: Микрофлора кишечника: причины нарушения и способы восстановления
Картинка 54: Диета для восстановления микрофлоры кишечника - программа диетического
Картинка 55: Микрофлора кишечника и ожирение / Микробиота и здоровье - YouTube
Картинка 56: Микрофлора кишечника и иммунная система #2 - YouTube
Картинка 57: Микрофлора кишечника
Картинка 58: Микрофлора желудочно-кишечного тракта
Картинка 59: Пин на доске Безуглеводная диета
Картинка 60: Анатомия на вътрешните органи на човешката коремна кухина

Диета горки отзывы

Лучшие жиросжигатели для спорта

Как похудеть 15 летней девушке

Бесплатно как похудеть за один день

Форум о эффективных диетах

Что можно есть чтобы похудеть при грудном вскармливании

Приготовление куриного филе при диете

Как фрукты и овощи помогают похудеть

Похудеть за один день на 2 3 килограмма

Как похудеть в животе за 3 дня на 4 кг

Во сколько нужно лечь спать чтобы похудеть

Если пить алкоголь похудеть

Похудеть возраст 55 лет

Хирург углов федор григорьевич диета

Можно ли от остеохондроза похудеть

Диета дюкана я сбросила

Как похудеть мне 15

На диету и фитнес
Как похудеть после родов без спорта

Можно катаясь на велосипеде похудеть каждый день